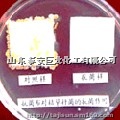

商品详情

甲壳素抗菌剂 涤纶抗菌剂 无机抗菌剂 纳米抗菌剂 鞋材抗菌剂
请选择 型号/数量
商品详情
JLSUN?抗菌整理后的织物具有明显的抗菌、消炎、防臭、防霉、止痒、收敛作用,对接触织物的MRSA、金黄色葡萄球菌、表皮葡萄球菌、淋球菌(国内流行株)、淋球菌(国际标准耐药株)、肺炎杆菌、大肠杆菌、绿脓杆菌、枯草杆菌、蜡状芽胞杆菌、白色念珠菌、絮状表皮癣菌、石膏样毛癣菌、红色毛癣菌、青霉菌、黑曲霉菌等有害菌的抑菌率高达99%以上,高度耐干洗和水洗;对皮肤无刺激性、无过敏反应,无毒,无致畸性,无致突变性,无潜在致癌性,不含甲醛和重金属离子等有害物质,符合环保要求,满足Oeko-Tex stand 100的标准;能有效地预防疾病通过织物传染,对防治脚癣、股癣、湿疹、疖痈、汗臭、脚臭、皮肤骚痒有显著效果。